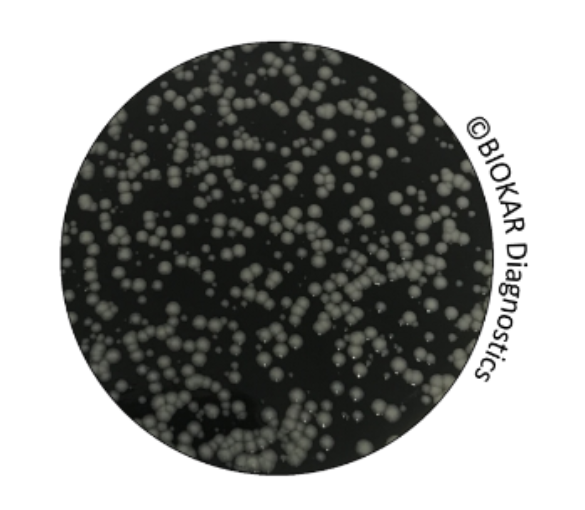

GVPC agar for Legionella được sử dụng để đếm, phân lập và nuôi cấy các loài Legionella trong nước sạch (nước nóng sản xuất, nước nóng vệ sinh, bể bơi…) và nước bẩn (nước công nghiệp, tháp giải nhiệt…).
Thành phần môi trường theo tiêu chuẩn NF T90-431 và NF EN ISO 11731.
NGUYÊN TẮC:
Chiết xuất nấm men tự phân tạo thành chất dinh dưỡng chính cho sự phát triển của Legionella.
Than hoạt tính phân hủy hydrogen peroxide (sản phẩm phụ chuyển hóa độc hại), thu giữ carbon dioxide và điều chỉnh sức căng bề mặt.
Bộ đệm ACES / KOH duy trì độ pH và cho phép ủ hiếu khí.
Cysteine và ferric pyrophosphate đại diện cho các yếu tố dinh dưỡng không thể thiếu cho sự phát triển của Legionella.
α-ketoglutarate là một chất kích hoạt tăng trưởng cho Legionella.
Hệ vi sinh thứ cấp bị ức chế bởi sự liên kết của glycine, vancomycin, polymyxin B và cycloheximide.

English